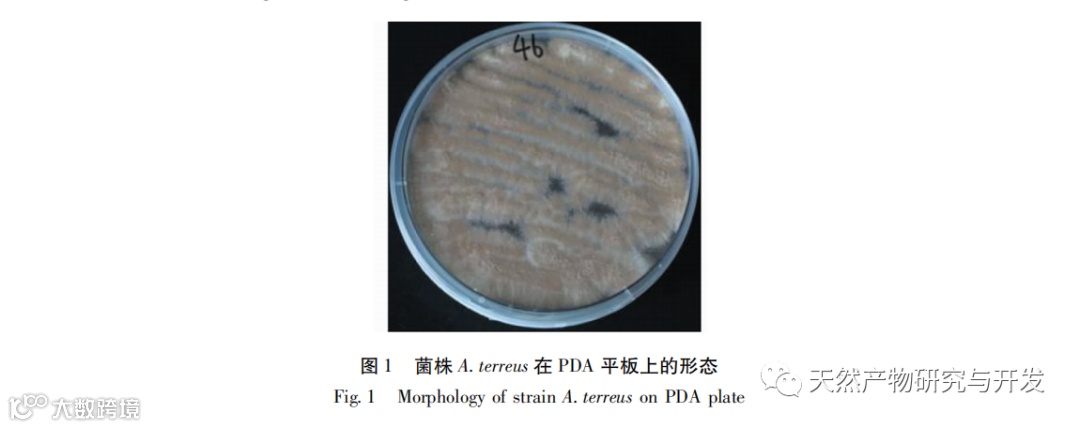

点击上方刊名关注我们
植物内生真菌(plant endophyte)是指生活在健康植物组织体内或生活史的某一阶段生活在植物组织体内,对宿主植物没有引起明显病害症状的一类微生物菌群。近几十年来,内生真菌已被证实具有合成独特的次级代谢产物的能力,成为近些年来天然产物领域研究的热点。植物内生真菌次级代谢产物具有结构多样、活性显著的特点。目前已从内生真菌中发现了具有抑菌、杀虫、抗肿瘤、抗氧化等活性的次级代谢产物,涵盖了聚酮类(大环内酯类、醌类、氧杂蒽酮类等)、萜类、生物碱类、肽类等多种结构类型。内生真菌在与宿主植物长期的协同进化过程中,能够产生与宿主相同或相似的活性成分。因此,药用植物内生真菌的研究引起了人们越来越多的关注。特别是从植物内生真菌中发现了众多抗肿瘤先导化合物或药物,如紫杉醇(taxol)、鬼臼毒素(podophyllotoxin)、喜树碱(camptothecin)等,表明从药用植物内生真菌中发掘新的抗肿瘤活性先导化合物具有较大的潜力。
太子参为石竹科植物孩儿参Pseudostellaria heterophylla (Miq) Pax的干燥块根,为我国常用传统中药,具有益气健脾、生津润肺等功效,用于治疗肺燥干咳、自汗口渴、脾虚体倦、食欲不振等症状。与其他药用植物相比,关于太子参内生真菌分离鉴定的研究较少。Cai等从太子参中分离获得18株内生真菌,其中有6株菌株发酵产物具有显著的抗肿瘤活性,3株菌株发酵产物具有较好的抗氧化活性。但是,目前缺乏对太子参内生真菌活性次级代谢产物的深入研究。为了研究内生真菌这一特殊的微生物资源,我们从太子参中分离获得了12株内生真菌,并对其次级代谢产物的多样性和活性进行了筛选分析。其中菌株Aspergillus terreus TZS-201607次级代谢产物具有丰富的化学结构多样性。在抗肿瘤活性筛选中,该菌株马铃薯葡萄糖肉汤(PDB)发酵产物对HeLa细胞表现出一定的抑制活性(48h抑制率>50%)。为从该菌株中获得具有抗肿瘤活性的次级代谢产物,本文对其化学成分及活性进行了进一步研究。

药用植物与其内生真菌通过长期的协同进化,形成了独特的互惠共生关系。其中,宿主植物为真菌提供生长、保护场所和营养环境,而内生真菌通过合成次级代谢产物促进植物的生长及防御。由于这些次级代谢产物具有显著的生物活性,极具新药开发前景,因此药用植物内生真菌资源已被证实是一个亟待开发的宝库。近30年来,已经从数百种药用植物,如宁前胡、川芎、夹竹桃等,分离纯化了大量的内生真菌,表明药用植物中蕴含着丰富的内生真菌资源。太子参作为我国常用传统中药,其关于内生真菌分离鉴定的研究较少,目前仅从中分离获得了18株内生真菌。因此,太子参内生真菌资源有待进一步深入发掘。
药用植物内生真菌能够产生结构多样的活性次级代谢产物,其中相当部分的次级代谢产物具有抗肿瘤药理活性,表现出潜在的应用价值。这些代谢产物的结构类型包括生物碱类、甾体类、萜类、黄酮类、蒽醌类等。蒽醌是天然醌类化合物中数量最多也是最重要的一类化合物,具有重要的生物活性,尤其抗肿瘤活性。其具有天然低毒、高效的特点,引起了研究人员广泛的关注。为了研究太子参内生真菌并从中获得活性显著的次级代谢产物,特别是发现具有抗肿瘤活性的化合物,本研究采用多种色谱技术从太子参内生真菌A.terreus TZS-201607中分离纯化得到16个化合物,分别为𠮿酮(化合物1~4)、蒽醌(化合物5~7)以及甾醇(化合物8~16)类化合物。本研究报道的化合物1~7、12、14~16为首次从内生真菌A.terreus中分离获得。在体外抗肿瘤活性测试中,化合物6、7和14对人肿瘤细胞株A549、BT-549、HeLa和THP-1表现出较强的细胞毒活性(IC50<10μM)。本研究丰富了太子参内生真菌资源多样性,在一定程度上丰富了真菌A.terreus次级代谢产物化学结构类型和生物活性。同时,本研究发现了抗肿瘤活性显著的蒽醌类化合物,为后续药物先导化合物的发现和研究提供了化合物实体。该研究成果发表在《天然产物研究与开发》2021年第7期,欢迎引用(点击左下方“阅读原文”可查看全文)。
引用格式:
胡晓峰,柴海全,贾林川,等.一株太子参内生真菌Aspergillus terreus TZS-201607中抗肿瘤活性代谢产物研究[J].天然产物研究与开发,2021,33:1156-1164.
Hu XF,Chai HQ, Jia LC,et al.Antitumor secondary metabolites of an endophytic fungus Aspergillus terreus TZS-201607 from Pseudostellaria heterophylla[J].Nat Prod Res Dev,2021,33:1156-1164.

长按二维码
关注公众号
获取更多内容

电话:028-85210304
官网:http://www.trcw.ac.cn
 点击阅读原文可查看全文
点击阅读原文可查看全文


